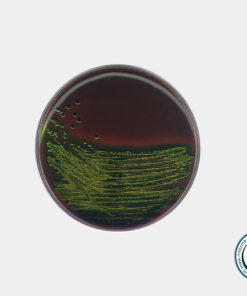
ائوزین متیلن بلو آگار EMB AGAR مرک کد 103858\ فروشگاه اینترنتی مستر آزما

محیط کشت EMB agar
محیط EMB یک محیط کشت انتخابی- افتراقی برای جداسازی کلی فرم ها و کلی فرم های مدفوعی بر اساس ایزو 20115 می باشد. ائوزین متیلن بلو آگار حاوی پپتون، لاکتوز، ساکارز و رنگ ائوزین Y و متیلن بلو است. فروش/خرید و قیمت به روز محیط کشت ائوزین متیلن بلو آگار EMB در فروشگاه مواد شیمیایی و آزمایشگاهی مسترآزما فقط در بسته بندی استاندارد شرکت سازنده (مرک-سیگما) صورت میگیرد.
رنگ های موجود در این محیط کشت باکتریایی مانع از رشد باکتری های گرم مثبت شده همچنین به عنوان شاخص های افتراقی برای محصولات تخمیری استفاده می شود و در شرایط اسیدی رنگ سبز متالیک را ایجاد می کند.
این محیط، در آزمایشگاههای پزشکی، با تشخیص میکروبهای بیماریزا در مدت زمانی کوتاه، اهمیت دارد.
محیط کشت سریع لاکتوز، اسیدهایی تولید میکند که پیاچ را کاهش میدهند. در نتیجه جذب رنگ توسط کلنیها را تشویق میکند که به رنگ بنفش مایل به سیاه هستند.
لاکتوز غیرتخمیری ممکن است پیاچ را با آمینزدایی پروتئینها افزایش دهد. در نتیجه، کلنیها، بیرنگ خواهند بود.
در این محیط، اگر اشریشیا کلی رشد کند، درخشش سبز متالیک متمایز ایجاد میکند (بهدلیل ویژگی متاکروماتیک رنگها، با استفاده از تاژک، و محصولات نهایی اسیدی قوی تخمیر). برخی از گونههای سیتروباکتر و انتروباکتر نیز، اینگونه به EMB واکنش نشان میدهند.این محیط، بهطور خاص برای جلوگیری از رشد باکتریهای گرم مثبت طراحی شدهاست. همچنین آگارهای EMB وجود دارند که حاوی لاکتوز نیستند.
برای اطلاعات بیشتر در مورد محیط کشت ها میتوانید مقاله محیط کشت ها چه هستند؟ در بخش مقالات علمی فروشگاه مسترآزما را مطالعه کنید.
کاربردهای ائوزین متیلن بلو آگار مرک
- در جداسازی کلی فرم ها
- برای جدا سازی باکتری های گرم منفی روده ای
- برای بررسی میکروبی محصولات لبنی
- کشت باکتری سالمونلا و شیگلا
- ایزوله کردن و افتراق باکتری های کلی فرم و کلی فرم های منفی
مواد تشکیل دهنده محیط کشت EMB آگار
- پپتون
- دی پتاسیم فسفات
- لاکتوز
- ساکاروز
- ائوزین Y
- متیلن بلو
- آگار
فروش ایوزین متیلن بلو آگار مرک کد 103858
فروشگاه مستر آزما به عنوان یکی از تامین کنندگان پیشگام محصولات شیمیایی و محیط های کشت از معتبرترین برندهای جهان آماده تامین و عرضه محیط کشت با کد 103858 با کیفیتی عالی و قیمتی رقابتی در مقادیر مختلف از کمپانی معتبر شرکت مرک – سیگما آلمان می باشد.
این کالا به همراه برگه آنالیز و ضمانت اصالت کالا به فروش می رسد.

دیدگاهها
هیچ دیدگاهی برای این محصول نوشته نشده است.